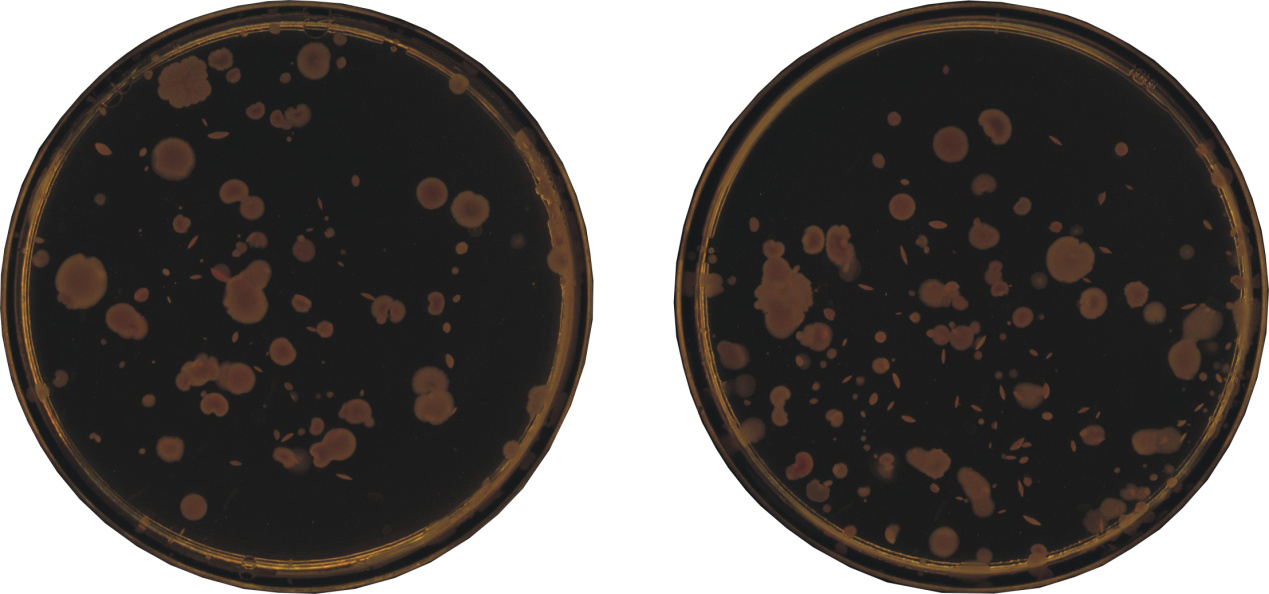

LK智能型全自动菌落计数仪是西安立科环保科技有限公司推出的第一代智能型菌落计数仪,仪器采用全封闭暗仓式拍照系统,全面消除了杂光对拍照效果的影响,光线柔和均匀无反光无暗点(图1);同时采用专业光源,使光照极大的接近自然光,还原菌落的真实色泽;高清晰相机结合高保真镜头细致捕捉每一个细小菌落的详细特征;采用人工智能计数算法,瞬时完成计数,专业的ColonyAnalyse菌落分析软件可以实现多类型计数、图像分割、菌落标注、数据保存、报告打印等复杂图像分析处理;灯箱可选装多波长紫外灯,具备荧光菌识别和杀菌功能,使您的工作变得更加简单高效。
统计效果:
ColonyAnalyse软件内置多种算法,可以实现不同颜色的培养基及不同特征的菌落的识别和复杂统计,并且设有灵敏度调节按钮,让用户通过调节灵敏度获得需要的统计效果。
统计区域:
ColonyAnalyse软件可以实现圆形、方形和多边形统计区域选择功能,用户可以通过选择不同形状,统计需要的平皿区域。
粘连分割:
ColonyAnalyse软件具有粘连分割功能,可以通过手动分割粘连的菌落,使统计结果更加精确。
区域删除:
ColonyAnalyse软件具有区域删除功能,可以通过手动自由选择区域删除不需要统计的菌落,获得需要统计的部分。
菌落标注:
ColonyAnalyse软件具有菌落标准功能,可以将培养皿中任意位置的菌落进行图片标注,把用户需要的信息标准在菌落上永久保存
数据保存:
ColonyAnalyse软件具有数据保存功能,每次处理完毕的菌落图片,通过输入样本名称、样本编号、接种量等信息,可以保存在数据库中,随时可以调取查看历史数据。
报告生成:
ColonyAnalyse软件具有报告生成功能,通过数据查询进入数据库,选择日期或者搜索样品名称等信息,可以快速查找数据,同时手动输入单位名称、项目名称、检验人、检验日期、方法名称、标准号等信息,点击报告即可生成PDF格式检验报告。